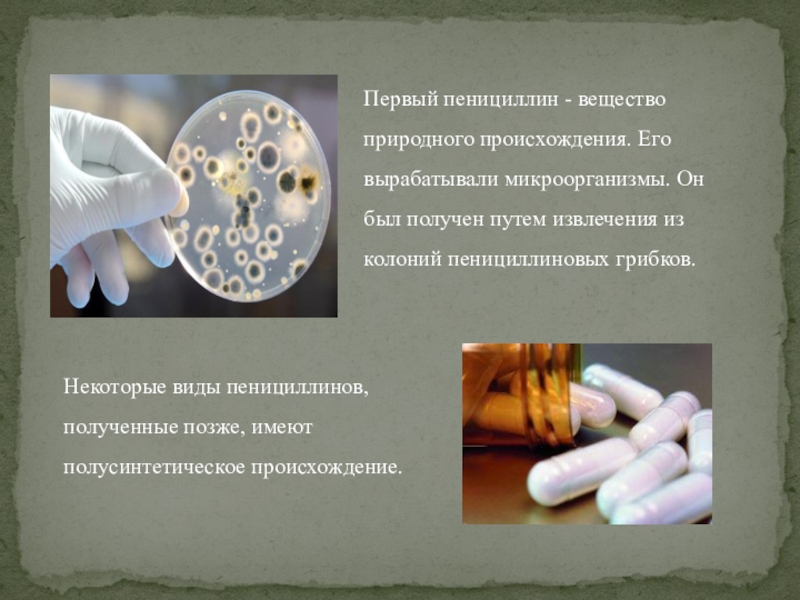

- Главная
- Разное
- Образование
- Спорт
- Естествознание
- Природоведение
- Религиоведение
- Французский язык
- Черчение
- Английский язык
- Астрономия
- Алгебра
- Биология
- География
- Геометрия
- Детские презентации
- Информатика
- История
- Литература
- Математика
- Музыка
- МХК
- Немецкий язык
- ОБЖ
- Обществознание
- Окружающий мир
- Педагогика
- Русский язык
- Технология
- Физика
- Философия
- Химия
- Шаблоны, фоны, картинки для презентаций
- Экология
- Экономика
Презентация, доклад по биологии на тему:Пенициллин
Содержание
- 1. Презентация по биологии на тему:Пенициллин
- 2. Александр Флеминг – британский бактериолог
- 3. В 1929 г. Александр Флеминг выращивал культуры
- 4. .
- 5. В 1942 году русский биолог Зинаида Виссарионовна
- 6. Пенициллин стал использоваться как лекарство только в
- 7. В 1945 г. А.Флеминг стал лауреатом Нобелевской премии.
- 8. Пенициллин - бактерицидный препарат. Он способен проникать
- 9. Первый пенициллин - вещество природного происхождения. Его
- 10. К природным пенициллинам относятся:
- 11. бензатин бензилпенициллин
- 12. Полусинтетические пенициллины впервые начали разрабатываться в 1957 г.
- 13. К полусинтетическим пенициллинам относятся:
- 14. Слайд 14
- 15. Антибиотики пенициллины принимают в виде уколов и
- 16. Пенициллин является одним их главных представителей группы
Слайд 3В 1929 г. Александр Флеминг выращивал культуры бактерий стафилококка в специальной
Слайд 4. С момента открытия пенициллина началась эпоха антибиотиков в медицине. Самое интересное,
Рисовал он не красками, а микробами, каждый вид которых имел свой яркий цвет. Эти виды микробов он рассеивал на специальное вещество. Но микробы расползались и портили картину. Так вот, границы между цветовыми слоями Флеминг делал из пенициллина, который убивал микробы.
Слайд 5В 1942 году русский биолог Зинаида Виссарионовна Ермольева получила пенициллин из
Слайд 6Пенициллин стал использоваться как лекарство только
в 1943 г. В США
Слайд 8Пенициллин - бактерицидный препарат. Он способен проникать в клетку бактерии, разрушая
Так и клетки бактерий начали защищаться от пенициллина, вырабатывая вещество бета-лактамазу. Тогда ученые разработали новый вид пенициллинов, который в состоянии уничтожить и бета-лактамазу. Такие пенициллины называются защищенными.
Слайд 9Первый пенициллин - вещество природного происхождения. Его вырабатывали микроорганизмы. Он был
Некоторые виды пенициллинов, полученные позже, имеют полусинтетическое происхождение.
Слайд 12Полусинтетические пенициллины впервые начали разрабатываться в 1957 г. на основе 6-аминопенициллановой кислоты,
Слайд 15Антибиотики пенициллины принимают в виде уколов и таблеток. Некоторые виды пенициллинов
Слайд 16Пенициллин является одним их главных представителей группы бета-лактамных антибиотиков, в которую
После открытия пенициллина были получены и другие антибиотики. Но пенициллин до сих пор считают одним из самых малотоксичных антибиотиков.